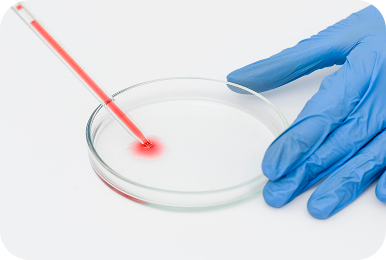
Анализ

Лаборатория «Экспресс Плюс» — ведущая отечественная медицинская лаборатория в Кыргызстане, предоставляющая широкий спектр лабораторных анализов с международным уровнем качества.

В 2000 году врач-дерматовенеролог, кандидат медицинских наук Жыпар Абдыказиевна Керималиева открыла медицинский центр «Авиценна» в скромном кабинете общежития музыкального института.
В Кыргызстане того времени остро не хватало качественной лабораторной диагностики. Работая с пациентами, мы пришли к простой истине: без надежной лабораторной базы невозможно выстроить эффективное лечение.
Так родилась лаборатория «Экспресс Плюс» — семейный проект, миссия которого — достоверные результаты анализов для каждого.
Путь становления был непростым
в условиях дефицита оборудования и реактивов мы выстраивали поставки из-за рубежа и внедряли современные технологии практически с нуля.1
Компания «Кокомерен» (2001) — обеспечение рынка медицинским оборудованием, реагентами и расходными материалами.2
Компания «Корпус» — собственное производство безопасной мебели для медицины, образования и офисов.
Керималиева Жыпар
врач-дерматовенеролог, кандидат медицинских наукМы предоставляем более 1000 видов лабораторных анализов, включая:

Более 20 лет опыта в лабораторной диагностике
Один из лидеров рынка медицинских анализов в Кыргызстане.
Точные результаты анализов
Соответствие международным стандартам качества и многоуровневый контроль.
Современное оборудование
Анализаторы ведущих мировых производителей.
Быстрые сроки выполнения
Оптимизированные процессы позволяют получать результаты максимально оперативно.
Широкая сеть лабораторий
Филиалы и пункты забора по всему Кыргызстану.
Удобство для пациентов
Выезд на дом, онлайн-доступ к результатам, консультации специалистов.Наши лаборатории соответствуют стандартам ВСО и имеют сертификацию ISO 9001. Мы - единственная лаборатория аккредитованная МАК ISQ UA №361.

Тысячи пациентов и врачей по всему Кыргызстану выбирают лабораторию «Экспресс Плюс» для диагностики и контроля здоровья.